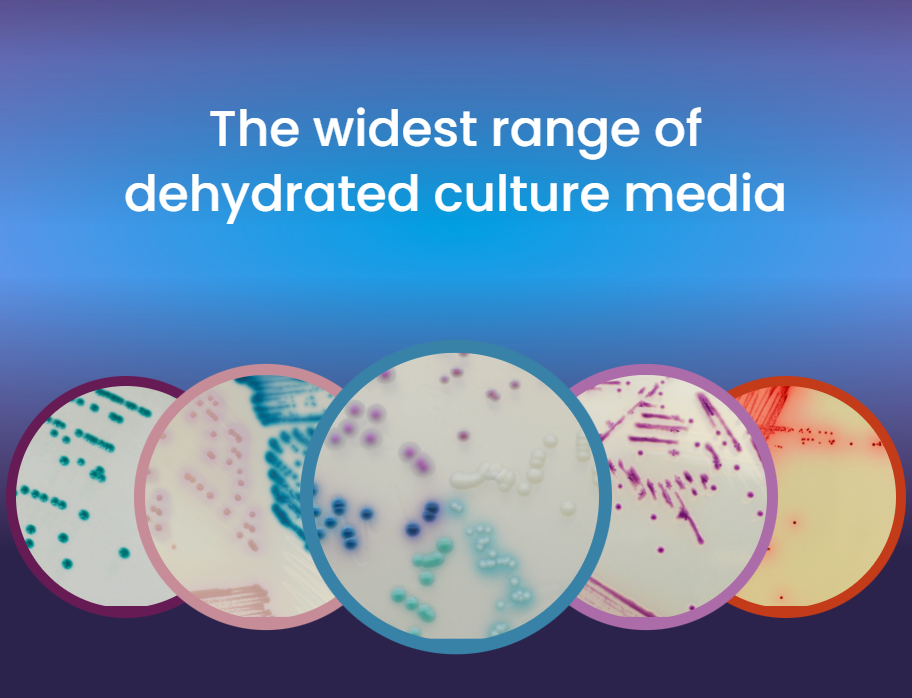

A SVT-Lab é uma divisão especializada da SVT, com foco na comercialização de uma vasta gama de equipamentos, materiais e consumíveis para laboratórios e hospitais, com especial atenção aos sectores da Saúde, Ensino, Investigação e Indústria na África Austral. Orgulhamo-nos de fornecer soluções inovadoras e diferenciadas, acompanhadas de um serviço de excelência e qualidade, que se destaca pela competitividade em termos de inovação, personalização e preço.
Satisfazer as necessidades dos nossos clientes mais exigentes através de um serviço excepcional, mantendo elevados padrões de qualidade nos productos que fornecemos.
Contribuir para uma humanidade em que a dignidade do homem seja a referência padrão, pois acreditamos que o maior erro que um homem pode cometer é sacrificar a sua saúde a qualquer outra vantagem.
Ser fornecedor de referência na África Austral nas áreas dos sectores da Saúde, Ensino, Investigação e Indústria.
Nossa equipe amigável e entusiasmada está de prontidão, ansiosa para conhecê-lo e ajudá-lo. Contacte-nos e deixe-nos cuidar das necessidades do seu laboratório e hospital.
A SVT-Lab é a representante oficial da CHROMagar™ e de outras marcas em Moçambique, uma marca internacional dedicada à produção da mais ampla gama de meios de cultura cromogênicos desidratados disponíveis. Esses meios cobrem aplicações em bacteriologia clínica, microbiologia industrial, controle de qualidade para as indústrias de alimentos e bebidas, testes de água, microbiologia veterinária e monitoramento ambiental.
Recipientes para misturar e analisar substâncias.
Amplia objectos pequenos para observação detalhada.
Reagente forte para síntese e análises laboratoriais.